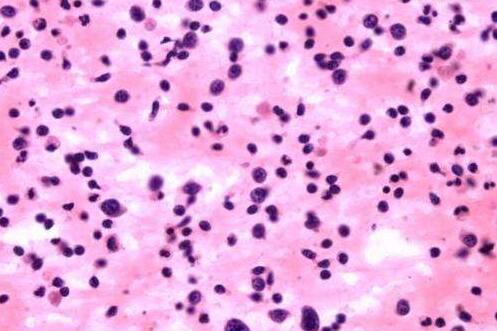
小儿紫癜是什么引起的

婴儿血小板减少性紫癜症状 婴儿紫癜的表现有哪些
2021年08月02日 19:18阅读次数:0
婴儿血小板减少性紫癜症状?婴儿血小板减少性紫癜会出现皮肤出血、黏膜出血或者内脏出现,如果严重的话可能会出现颅内出血。
婴儿血小板减少性紫癜症状?婴儿血小板减少性紫癜会出现皮肤出血、黏膜出血或者内脏出现,如果严重的话可能会出现颅内出血。
婴儿血小板减少性紫癜是出现在婴儿身上的一种疾病,这种疾病的出现跟染色体异常有很大关系。在人体的血小板功能遭到破坏后,血小板的数值就会下降,当下降到一定的数值就会引发各种各样的症状。那婴儿血小板减少性紫癜症状有哪些呢?
首先,出血是血小板减少性紫癜的发病所会带来的典型症状之一。由于血小板减少性紫癜的发生会导致婴儿体内的血小板发生消耗性的减少情况,因此婴儿会出现皮肤出血、粘膜出血以及内脏出血的症状,部分病情比较严重的婴儿甚至还会出现颅内出血的状况。

其次,神经精神症状也是血小板减少性紫癜所会带来的症状之一,其主要表现为意识紊乱、嗜睡、精神紊乱以及昏迷等,部分婴儿可能还会出现脑神经麻痹、偏瘫等异常的情况,虽然说这种神经精神症状会在一段时间内恢复,但是也绝对不能忽视。
此外,血小板减少性紫癜的发生还会导致发热这种症状发生。按照不同的情况可以将血小板减少性紫癜分为急性血小板减少性紫癜和慢性血小板减少性紫癜两种类型,无论是哪一种类型的血小板减少性紫癜都会引发发热的症状出现。
最后,皮肤症状是血小板减少性紫癜的一种主要的症状。在受到血小板减少性紫癜侵害之后,婴儿的皮肤会出现皮肤紫癜、皮肤瘀斑、淤点等表现,而且这些皮肤症状分布均匀。
- 紫癜
- 常见疾病
- 疾病

11:11
11:11
 12:51
12:51
 10:12
10:12
 15:15
15:15
 15:17
15:17











还没有人评论哦,赶紧抢一个沙发吧!